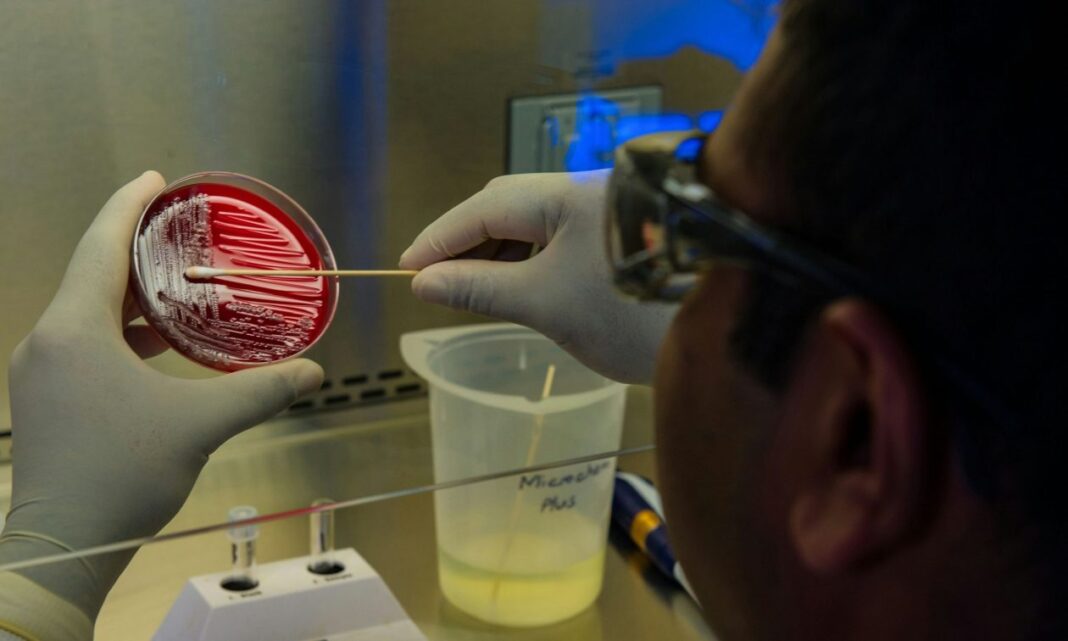

Τα βακτήρια μπορούν να προκαλέσουν πλήθος συμπτωμάτων, όπως φουσκάλες, εξανθήματα, διάρροια, μυϊκή αδυναμία και ηπατική βλάβη
Η κλιματική αλλαγή θερμαίνει τις κάποτε ψυχρές λίμνες και τις δεξαμενές, τροφοδοτώντας την αύξηση των επικίνδυνων επιδημιών βακτηρίων και της άνθισης των φυκιών.
Σύμφωνα με το Bloomberg, τα βακτήρια τείνουν να αναπτύσσονται σε θερμές συνθήκες και μεταξύ 1985 και 2009, οι λίμνες και οι λίμνες θερμάνθηκαν με ρυθμό περίπου 0,3C ανά δεκαετία. Αυτή η αλλαγή αυξάνει τον κίνδυνο σε ιστορικά ψυχρά μέρη. Τα βακτήρια μπορούν να προκαλέσουν πλήθος συμπτωμάτων, όπως φουσκάλες, εξανθήματα, διάρροια, μυϊκή αδυναμία και ηπατική βλάβη, για να αναφέρουμε μερικά από αυτά. Οι επιδημίες μπορούν επίσης να επιβαρύνουν τα οικοσυστήματα.
Οι έντονες βροχοπτώσεις συχνά παρέχουν τα «καύσιμα και τις προμήθειες» για τις βακτηριακές αιχμές, σύμφωνα με την Kaitlin Reinl, λιμνολόγο στην Εθνική Υπηρεσία Ωκεανών και Ατμόσφαιρας.
Τα νερά της βροχής προωθούν τη βακτηριακή ανάπτυξη με το ξέπλυμα φωσφόρου και αζώτου σε λίμνες και ποτάμια, όπου τα κύματα καύσωνα μπορούν να οδηγήσουν στην ανάπτυξη βακτηρίων και φυκιών.
«Βασικά, η θερμοκρασία επιταχύνει τα πάντα», λέει ο Χανς-Πέτερ Γκρόσαρτ, καθηγητής υδάτινης μικροβιακής οικολογίας και βιοποικιλότητας στο Πανεπιστήμιο του Πότσδαμ. «Η ισορροπία του διοξειδίου του άνθρακα στο νερό έχει αλλάξει, επειδή τώρα έχουμε υψηλότερες συγκεντρώσεις CO2 στην ατμόσφαιρα. Το [φαινόμενο] του θερμοκηπίου αυξάνει τη συγκέντρωση θρεπτικών συστατικών (π.χ. παρουσία φωσφόρου και αζώτου στο νερό) και τη συγκέντρωση CO2».
Μια από τις πιο συνηθισμένες βακτηριακές απειλές για την ποιότητα του νερού είναι το διαρροιογόνο E. coli, το οποίο ευδοκιμεί σε θερμότερες συνθήκες: Κάθε αύξηση της μέσης μηνιαίας θερμοκρασίας κατά 1C αυξάνει τη συχνότητά του κατά 8%.